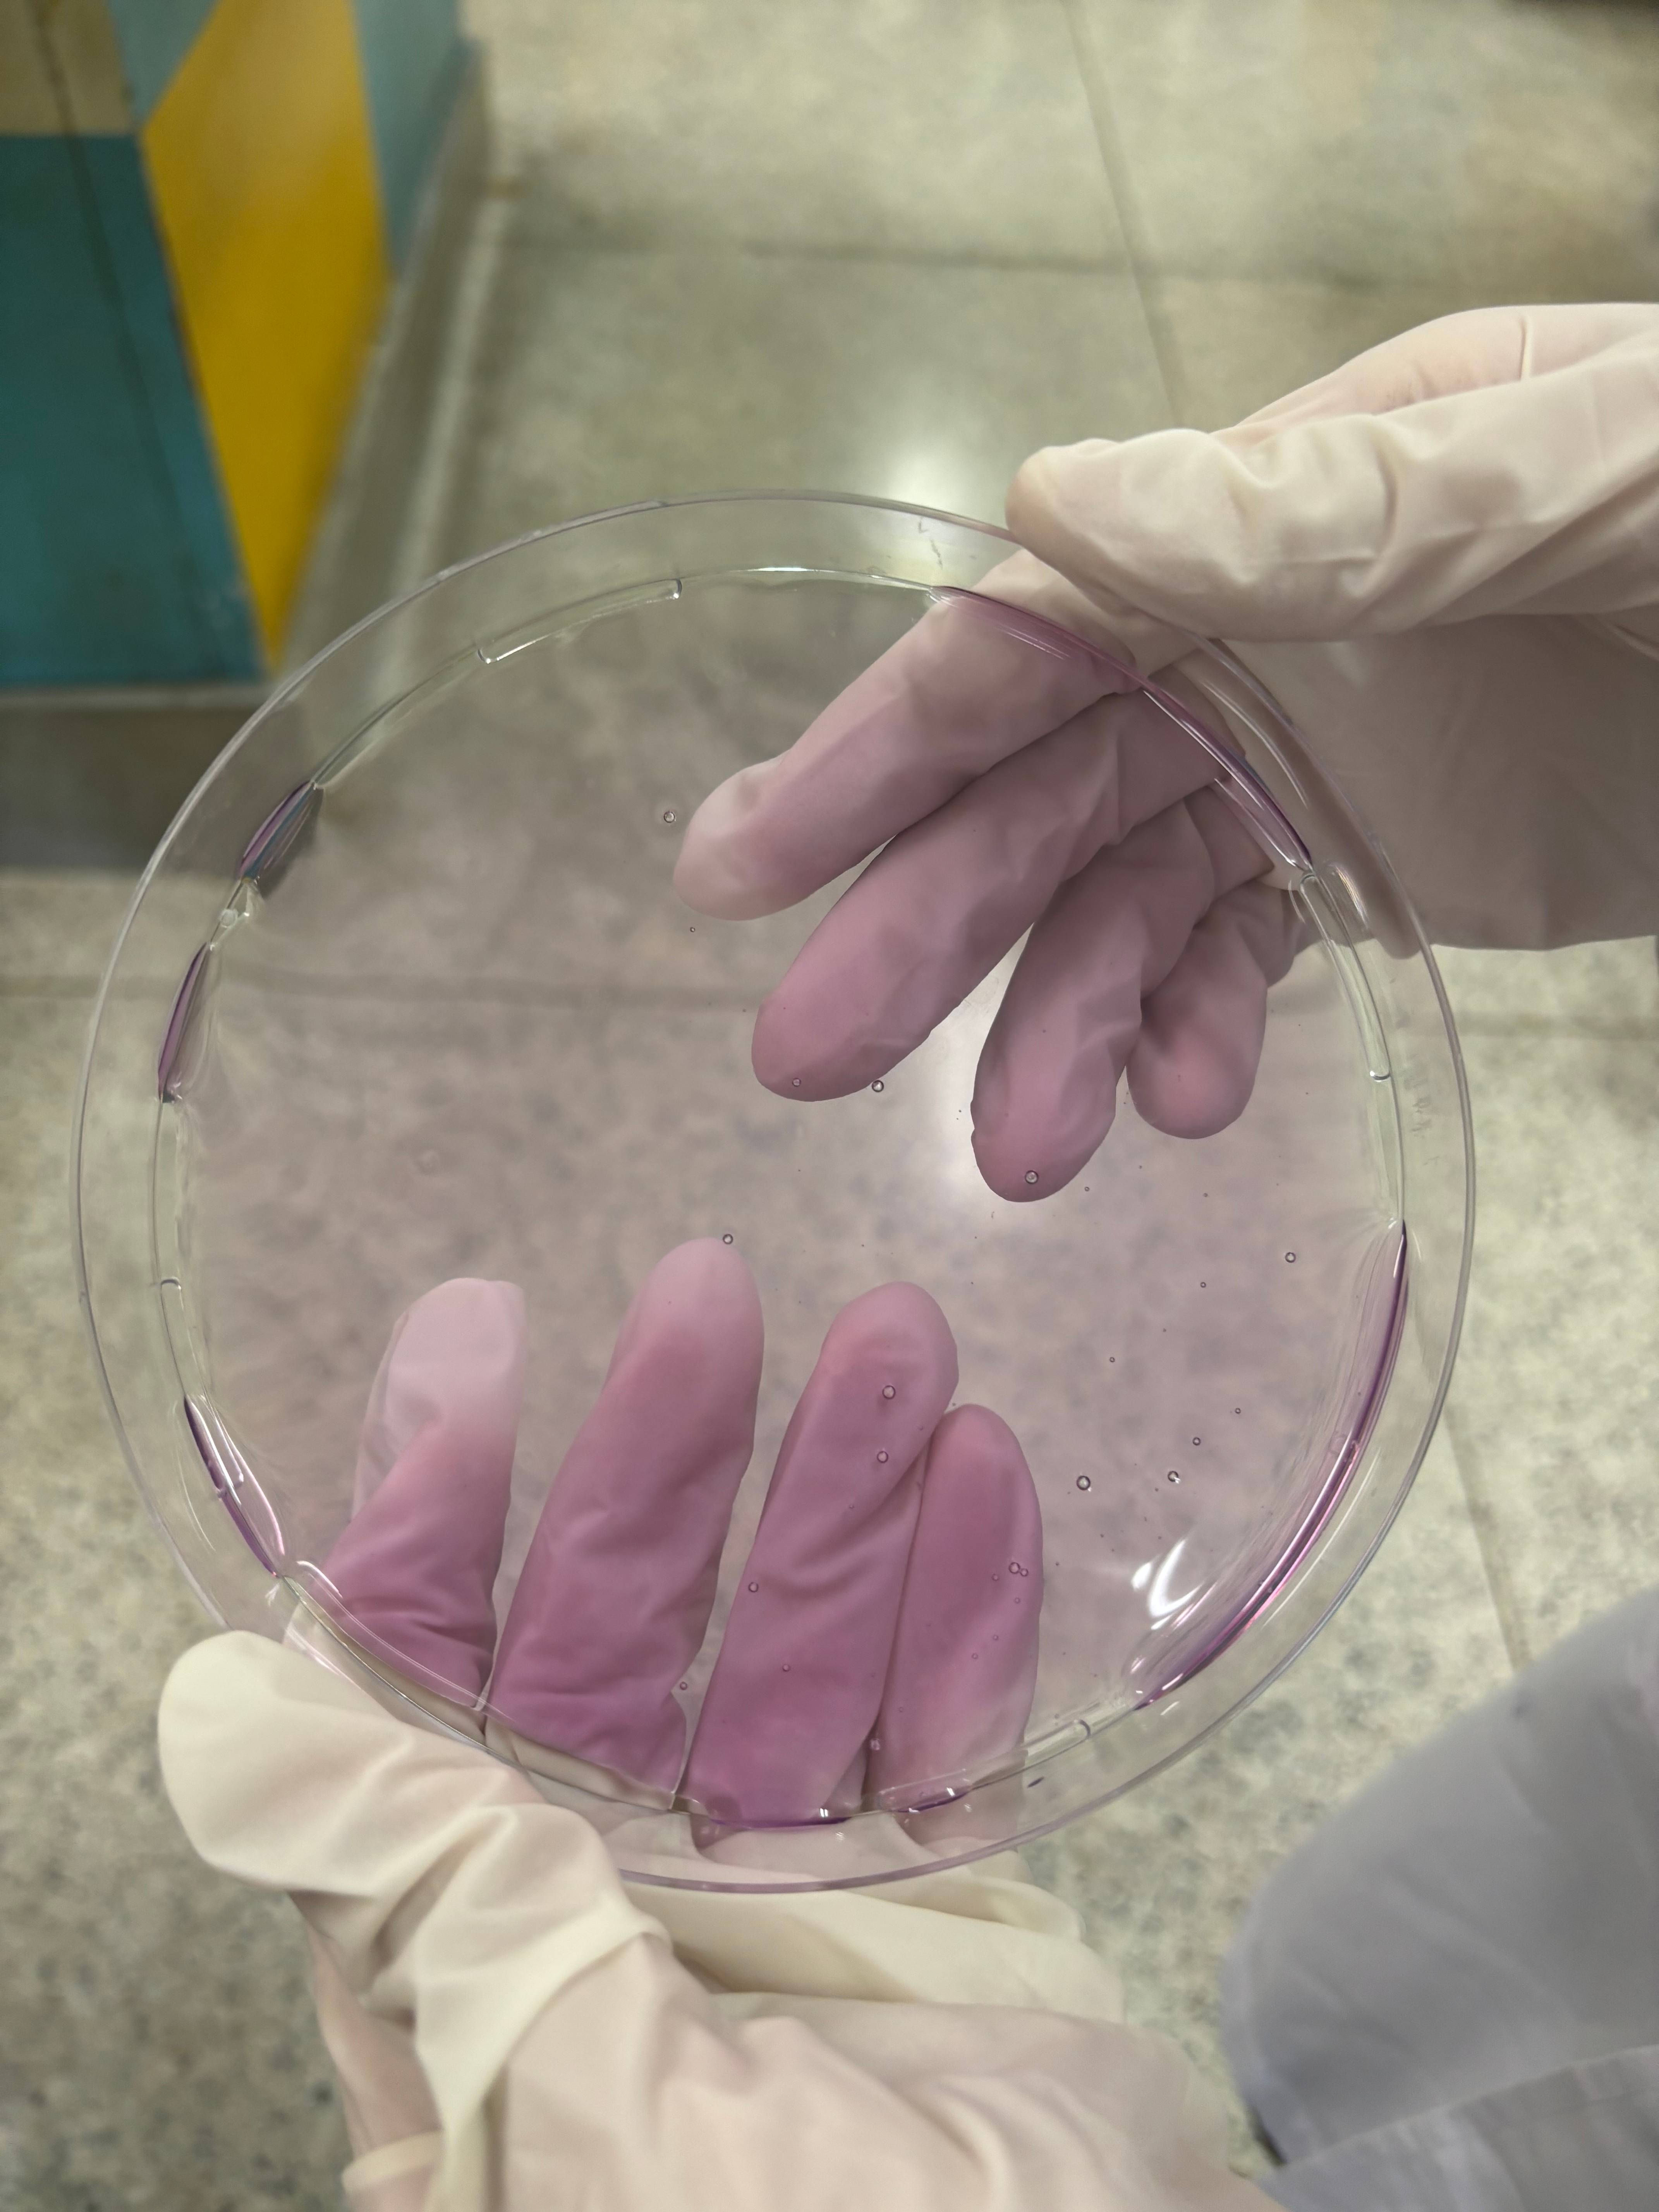

Hydrogel Patch for Infection Detection in Wounds
Siriluck Khaviriyakoson | Thailand
Hydrogel Patch for Infection Detection in Wounds
Siriluck Khaviriyakoson
Thailand
Detail
This study introduces BIO TONE, a pH-responsive hydrogel patch incorporating plant-derived anthocyanins for early wound infection detection. Anthocyanins from purple cabbage, roselle, and riceberry exhibited defined pH-dependent spectral shifts via UV–Vis analysis. The hydrogel enabled visible differentiation of pathogenic bacteria within 2 hours, and the integrated smartphone analytics system provided low-cost, accessible classification for diabetic wound monitoring.